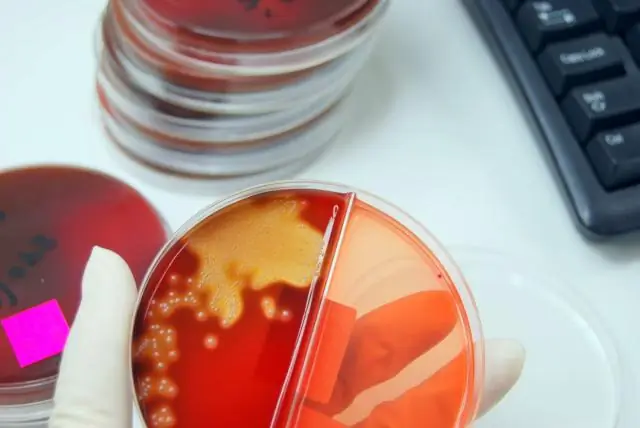
Выявлена причина устойчивости к антибиотикам

Ученые впервые подтвердили, что бактерии могут изменять форму, чтобы избежать обнаружения антибиотиками в организме человека.
Изучая образцы пожилых пациентов с рецидивирующими инфекциями мочевыводящих путей, команда Университета Ньюкасла использовала самые современные методы, чтобы определить, что бактерии могут терять свою клеточную стенку, что является общей мишенью для многих групп антибиотиков.
Исследование лаборатории Эррингтона, которое переворачивает с ног на голову современные представления о способности бактерий выживать без клеточной стенки, известное как «переключение L-формы», опубликовано сегодня в Nature Communications.
Всемирная организация здравоохранения определила устойчивость к антибиотикам как одну из самых больших угроз глобальному здравоохранению, продовольственной безопасности и развитию на сегодняшний день.
Ведущий автор, доктор Катажина Мицкевич, исследователь из Ньюкаслского университета, сказала: «Представьте, что стена подобна бактериям, одетым в светоотражающую оболочку. Это придает им правильную форму (например, стержень или сферу), что делает они сильные и защищают их, но также делают их очень заметными - особенно для иммунной системы человека и антибиотиков, таких как пенициллин.
Мы видели, что в присутствии антибиотиков бактерии способны изменяться от очень регулярной формы со стенками до полностью случайного состояния L-формы с дефицитом клеточной стенки - по сути, сбрасывая желтую окраску. куртку и прячут ее внутри себя.
"В этой форме организм не может легко распознать бактерии, поэтому не атакует их, как и антибиотики."
L-форма - хлипкая, но выживает
Исследование, в котором использовались образцы, полученные в сотрудничестве с клиницистами в больнице Ньюкасл Фриман, входящей в состав Фонда больниц Ньюкасл-апон-Тайн, организованное доктором Филиппом Олдриджем и доктором Джудит Холл, показывает, что при наличии антибиотиков, например, у пациента при ИМП, получающей пенициллин или другой антибиотик, воздействующий на клеточную стенку, - тогда бактерии имеют способность изменять форму, теряя клеточную стенку, которая часто является мишенью для антибиотика.
В предыдущей публикации, появившейся в Cell в 2018 году (10.1016/j.cell.2018.01.021), команда Errington продемонстрировала, что наша иммунная система также может в некоторой степени вызывать переключение L-формы, но лечение антибиотиками имеют гораздо более глубокий эффект. Текущее исследование показало, что L-формы различных видов бактерий, обычно связанных с ИМП, включая E. coli, Enterococcus, Enterobacter и Staphylococcus, обнаруживались у 29 из 30 пациентов, участвовавших в исследовании.
В этой L-форме бактерии непрочные и слабые, но некоторые выживают, прячась внутри тела.
Исследование также впервые зафиксировало на видео, как бактерии L-формы, выделенные от пациента с ИМП, восстанавливают клеточную стенку после прекращения действия антибиотика, что занимает всего 5 часов. Команда также смогла показать с помощью прямой микроскопии на модели прозрачной рыбки данио, что переключение L-формы возможно в контексте всего живого организма, а не только в искусственных условиях в лаборатории.
Д-р Мицкевич объяснил: «У здорового пациента это, вероятно, будет означать, что оставшиеся бактерии L-формы будут уничтожены иммунной системой их хозяев. Но у ослабленного или пожилого пациента, как в наших образцах, L -form могут выжить. Затем они могут восстановить свою клеточную стенку, и пациент снова сталкивается с другой инфекцией. И это вполне может быть одной из основных причин, почему мы видим людей с рецидивирующими ИМП.
"Для врачей это может означать рассмотрение комбинированного лечения - например, антибиотик, который воздействует на клеточную стенку, а затем другой тип для любых скрытых бактерий L-формы, то есть тот, который воздействует на РНК или ДНК внутри или даже на окружающую мембрану.."
Диагноз
Исследование также показало, что бактерии L-формы трудно идентифицировать традиционными методами, используемыми в больницах, поскольку гель, используемый, по сути, «выталкивает» бактерии, когда они помещаются в него.
Специальный осмозащитный метод обнаружения был необходим для поддержки более слабых бактерий L-формы, позволяющих идентифицировать их в лаборатории.
Команда будет продолжать исследование, проводя испытания на пациентах, прошедших курс лечения.